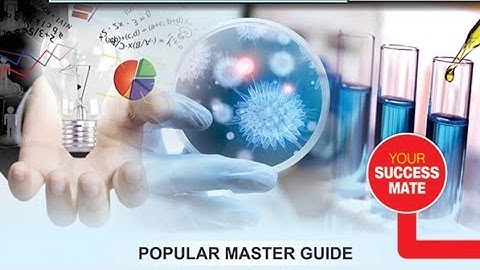
GATE 2020 Chemistry (Fully Solved) with Detailed Solutions - IIT Delhi 2020

⬇ DOWNLOAD NOW
Kalau muncul iklan pop-up, tutup lalu klik tombol kembali
Download lagu IIT DELHI GATE 2020, IIT DELHI GATE 2020 ANSWER KEY, IIT DELHI GATE 2020 RESULT secara gratis hanya untuk keperluan promosi. Dukung artis favorit kamu dengan membeli musik original di iTunes atau platform resmi lainnya.
 GATE 2020 by IIT DELHI Solutions & Answer Key
GATE 2020 by IIT DELHI Solutions & Answer Key
 GATE 2020 OFFICIAL ANSWER KEY RELEASED FROM IIT DELHI|LIFE SCIENCE|ALL SUBJECTS|GATE RESULT|
GATE 2020 OFFICIAL ANSWER KEY RELEASED FROM IIT DELHI|LIFE SCIENCE|ALL SUBJECTS|GATE RESULT|
 GATE 2020 OFFICIAL TEST BY IIT DELHI
GATE 2020 OFFICIAL TEST BY IIT DELHI
 How to check gate result 2020 | gate 2020 result link | IIT Delhi gate 2020 result
How to check gate result 2020 | gate 2020 result link | IIT Delhi gate 2020 result
 How IITians study😂 | IIT Delhi
How IITians study😂 | IIT Delhi
 GATE 2020 Result Announced | What to do with GATE Score | Which IIT to Apply
GATE 2020 Result Announced | What to do with GATE Score | Which IIT to Apply
GATE 2020 Chemistry (Fully Solved) with Detailed Solutions - IIT Delhi 2020
GATE 2020 Chemistry (Fully Solved) with Detailed Solutions - IIT Delhi 2020
 IIT DELHI GATE 2020 का पेपर सेट कर रहा है
IIT DELHI GATE 2020 का पेपर सेट कर रहा है